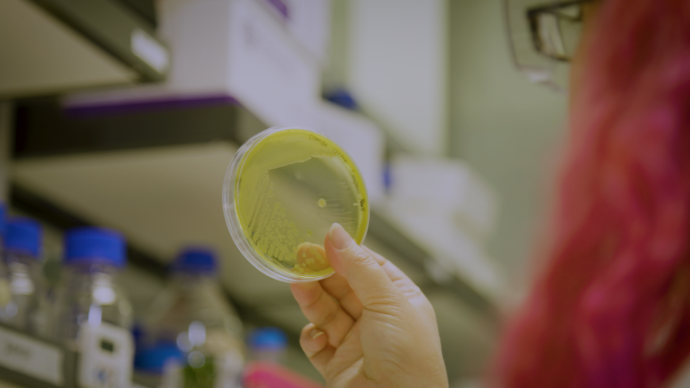

News
Published 17 May 2017VIDEO Antimicrobial resistance: a major health issue
New Zealand is as vulnerable as all countries to the global growth in antimicrobial resistance that is making some diseases untreatable.
Dr Siouxsie Wiles, a microbiologist from the University of Auckland, a Royal Society Te Apārangi Councillor and an expert adviser on the report on antimicrobial resistance produced by Royal Society Te Apārangi explains why it is such a big issue for us.
Source: Royal Society Te Apārangi
